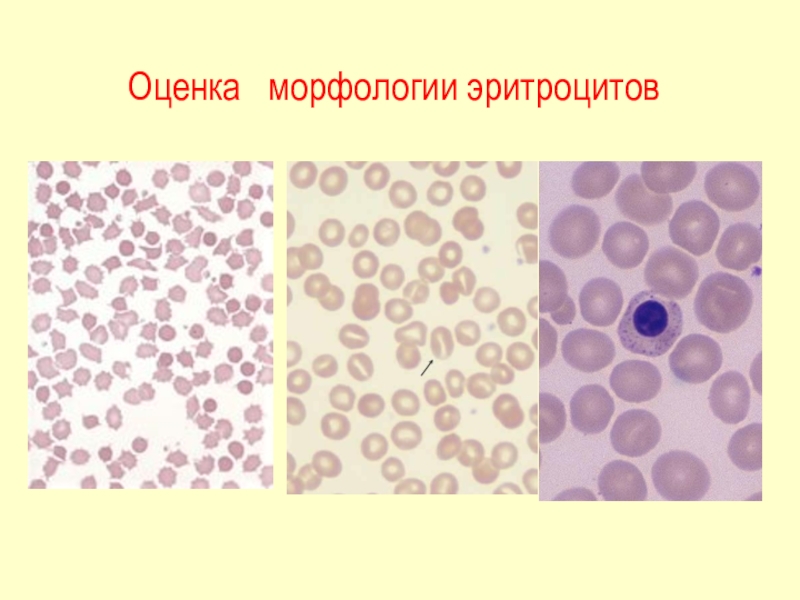
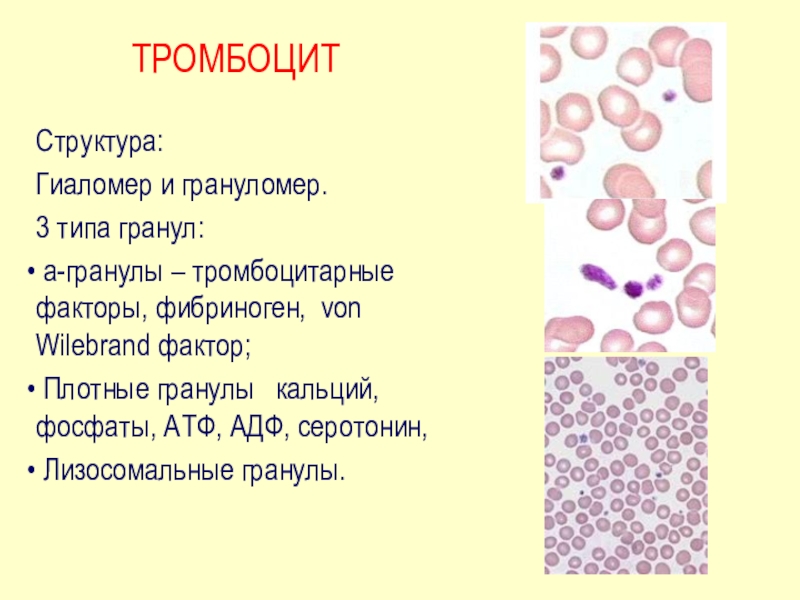
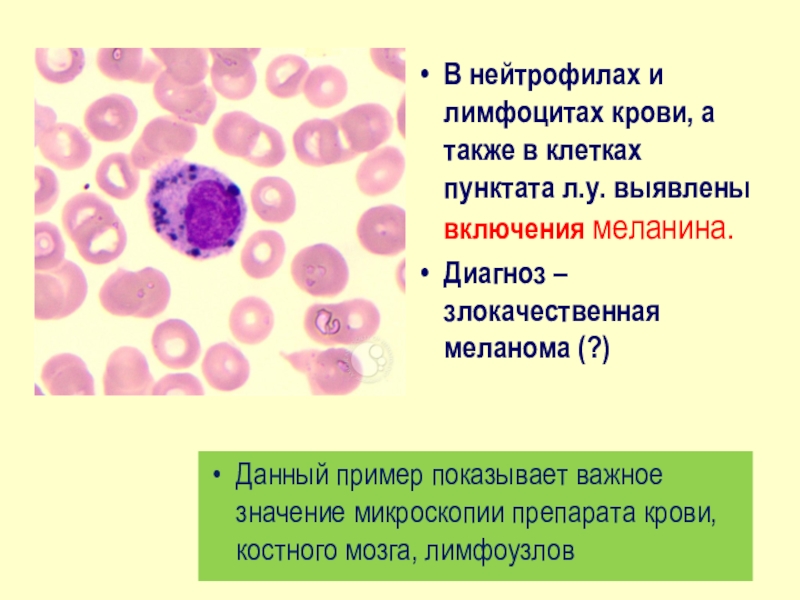

лейкоцитов( У.Хевсон)
1870 – счетная камера (Л.Малассе)
1877 – первое описание тромбоцитов
(Ж. Гайем)1902 – красители Май-Грюнвальда, Гимза
1904 – соотношение лейкоцитов (Д.Арнет)
1917 – А.А.Максимов
1957 – первый счетчик клеток крови
1983 – гематологический анализатор (3DIFF)